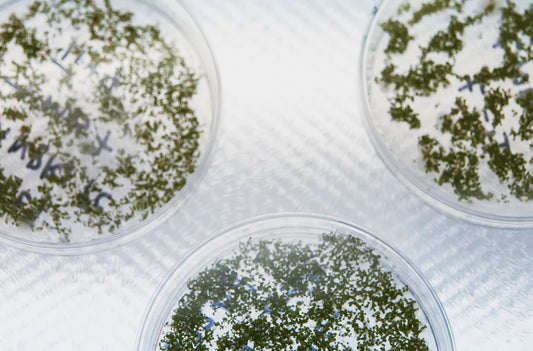

Learn Plant Tissue Culture Techniques
More on Agar Tissue Culture
What is Agar? Agar is a mixture of agarose and agaropectin, where agarose is a linear polysaccharide and agaropectin is a heterogenous sulfated galactan mixture. These are obtained from the...
More on Agar Tissue Culture
What is Agar? Agar is a mixture of agarose and agaropectin, where agarose is a linear polysaccharide and agaropectin is a heterogenous sulfated galactan mixture. These are obtained from the...

PPM™ in Action: An Experiment on PPM™ Effective...
Contamination is the biggest and most common challenge in tissue culture labs or rooms. The primary requirement for tissue culture is to maintain aseptic conditions. We spend a lot of...
PPM™ in Action: An Experiment on PPM™ Effective...
Contamination is the biggest and most common challenge in tissue culture labs or rooms. The primary requirement for tissue culture is to maintain aseptic conditions. We spend a lot of...

How to Make Tissue Culture Agar
What is Agar? Agar is a mixture of agarose and agaropectin, where agarose is a linear polysaccharide and agaropectin is a heterogenous sulfated galactan mixture. These are obtained from the...
How to Make Tissue Culture Agar
What is Agar? Agar is a mixture of agarose and agaropectin, where agarose is a linear polysaccharide and agaropectin is a heterogenous sulfated galactan mixture. These are obtained from the...

Tissue Culture of Teak Plants (Tectona grandis)
Tectona grandis, also commonly known as teak trees, have been used extensively in some countries for more than 2000 years. Teak trees belong to the family of Verbenaceae and are...
Tissue Culture of Teak Plants (Tectona grandis)
Tectona grandis, also commonly known as teak trees, have been used extensively in some countries for more than 2000 years. Teak trees belong to the family of Verbenaceae and are...

Plant Embryo Culture and Tissue Culture Applica...
An embryo is a part of the seed that forms after double fertilization and contains the pre-form of the plant organs. It is cultured in the artificial environment or laboratory...
Plant Embryo Culture and Tissue Culture Applica...
An embryo is a part of the seed that forms after double fertilization and contains the pre-form of the plant organs. It is cultured in the artificial environment or laboratory...

Temporary Immersion Bioreactors
Tissue culture is a useful technique to produce high-quality plants or plants with desired characteristics on large scale. The problem associated with the technique is the requirement of intensive labor,...
Temporary Immersion Bioreactors
Tissue culture is a useful technique to produce high-quality plants or plants with desired characteristics on large scale. The problem associated with the technique is the requirement of intensive labor,...